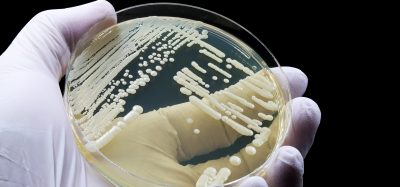
Laboratory culture of fungal pathogens such as Candida auris used in antifungal resistance research.

Making immunotherapy safer and more accessible through continuous digital monitoring
Immunotherapies such as CAR-T are extending survival, yet reliance on inpatient monitoring for cytokine release syndrome continues to restrict access. This article explores how continuous digital monitoring and AI-driven analysis could enable safer outpatient delivery and support more scalable immunotherapy adoption.